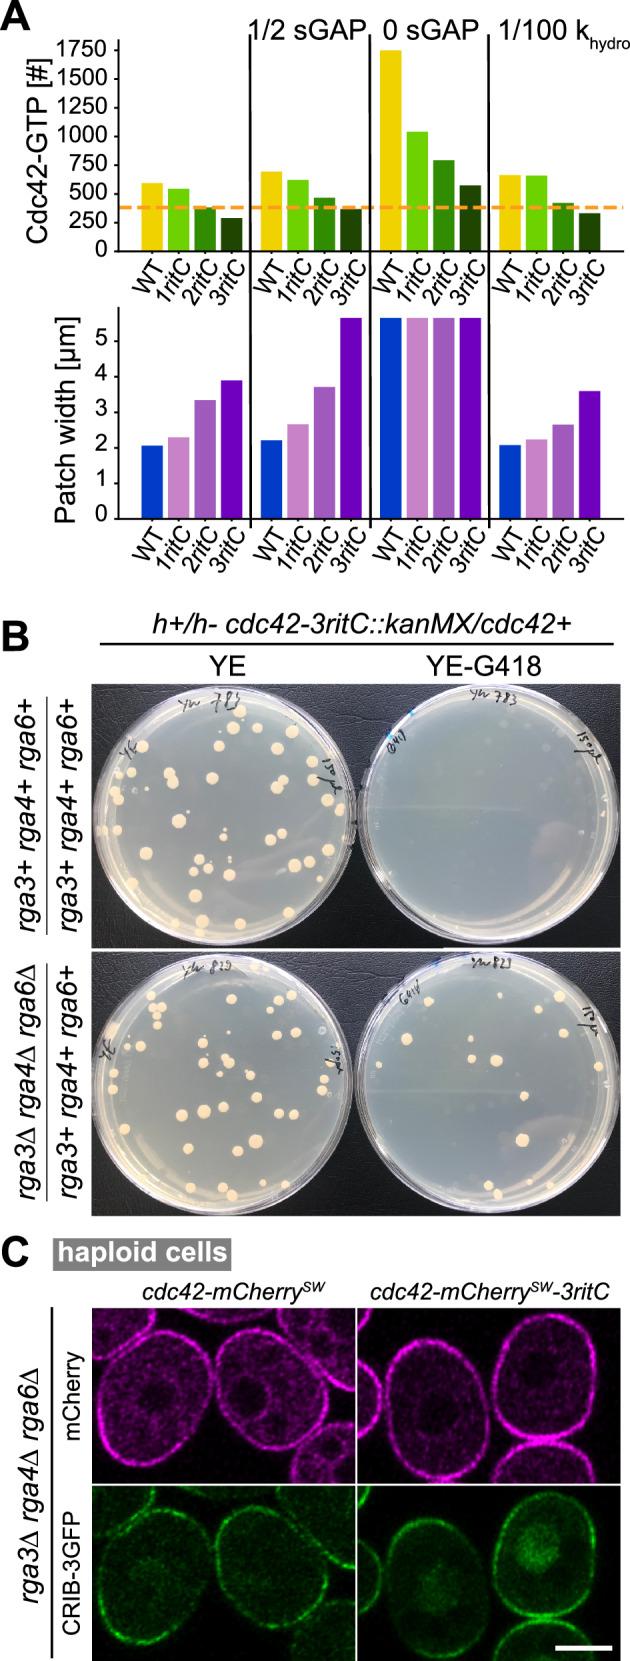
https://cdn.ncbi.nlm.nih.gov/pmc/blobs/04de/11437197/99f577cb383c/41467_2024_52655_Fig4_HTML.jpg

Cdc42 的迁移和膜流调节酿酒酵母的细胞形状和存活。
Cdc42 mobility and membrane flows regulate fission yeast cell shape and survival.
机构信息
Department of Physics, Lehigh University, Bethlehem, PA, USA.
Department of Fundamental Microbiology, University of Lausanne, Lausanne, Switzerland.
出版信息
Nat Commun. 2024 Sep 27;15(1):8363. doi: 10.1038/s41467-024-52655-1.
Polarized exocytosis induced by local Cdc42 GTPase activity results in membrane flows that deplete low-mobility membrane-associated proteins. A reaction-diffusion particle model comprising Cdc42 positive feedback activation, hydrolysis by GTPase-activating proteins (GAPs), and flow-induced displacement by exo/endocytosis shows that flow-induced depletion of low mobility GAPs promotes polarization. We modified Cdc42 mobility in Schizosaccharomyces pombe by replacing its prenylation site with 1, 2 or 3 repeats of the Rit C-terminal membrane-binding domain (ritC), yielding alleles with progressively lower mobility and increased flow-coupling. While Cdc42-1ritC cells are viable and polarized, Cdc42-2ritC polarize poorly and Cdc42-3ritC are inviable, in agreement with model's predictions. Deletion of Cdc42 GAPs restores viability to Cdc42-3ritC cells, verifying the model's prediction that GAP deletion increases Cdc42 activity at the expense of polarization. Our work demonstrates how membrane flows are an integral part of Cdc42-driven pattern formation and require Cdc42-GTP to turn over faster than the surface on which it forms.
局部 Cdc42 GTP 酶活性诱导的极化胞吐作用导致膜流,从而耗尽低迁移率的膜相关蛋白。一个包含 Cdc42 正反馈激活、GTP 酶激活蛋白(GAPs)水解和胞吐/胞吞引起的流动位移的反应扩散粒子模型表明,流动诱导的低迁移率 GAP 的耗竭促进了极化。我们通过用 Rit C 末端膜结合结构域(ritC)的 1、2 或 3 个重复取代酿酒酵母的 Cdc42 的 prenylation 位点来改变 Cdc42 的迁移率,得到了迁移率逐渐降低且流动耦合增加的等位基因。虽然 Cdc42-1ritC 细胞是存活和极化的,但 Cdc42-2ritC 极化不良,Cdc42-3ritC 则是不可存活的,这与模型的预测一致。Cdc42 GAP 的缺失恢复了 Cdc42-3ritC 细胞的活力,这验证了模型的预测,即 GAP 的缺失以牺牲极化的代价增加了 Cdc42 的活性。我们的工作表明,膜流是 Cdc42 驱动的模式形成的一个组成部分,并且需要 Cdc42-GTP 比它形成的表面更快地周转。